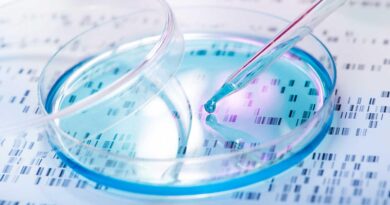

Camera Deputaţilor şi Senatul, şedinţă comună pentru eliminarea pensiillor speciale ale parlamentarilor. Participă premierul Marcel Ciolacu. PSD şi PNL, şedinţe ale forurilor de conducere înaintea plenului
Camera Deputaţilor şi Senatul se reunesc, luni, în şedinţă comună, în prezenţa premierului Marcel Ciolacu, având pe ordinea de zi eliminarea pensiilor speciale ale parlamentarilor. Înaintea plenului, se vor reuni în şedinţe structurile de conducere ale PNL şi PSD.
Şedinţa comună a Camerei Deputaţilor şi Senatului este programată la ora 14.00.
Pe ordinea de zi se află propunerea legislativă pentru abrogarea Capitolului XI din Legea nr.96/2006 privind Statutul deputaţilor şi al senatorilor (Pl-x 411/2023; L 382/2023), care se dezbate în procedură de urgenţă.
„Dorim o reaşezare pe baze solide, atât a sistemului de pensii de serviciu, cât şi a sistemului de indemnizaţii pentru limită de vârstă acordate parlamentarilor care şi-au încheiat exercitarea unuia sau mai multor mandate. De aceea, e nevoie de măsuri legislative care să şteargă inechităţile din sistem, eliminarea indemnizaţiei pentru limită de vârstă a parlamentarilor fiind una din aceste măsuri de înlăturare a discriminării faţă de persoanele care beneficiază de pensii pe criteriul contributivităţii”, se arată în Expunerea de motive a proiectului legislativ.
„Totodată având în vedere situaţia de criză prin care trece ţara noastră ca urmare a efectelor economice post-pandemie, dar şi a conflictului din Ucraina cu consecinţe economice majore şi asupra ţării, considerăm că parlamentarii ar trebui să fie primii care dau dovadă de solidaritate şi respect în cheltuirea banului public în vederea redobândirii încrederii populaţiei în instituţiile publice în general şi în instituţia parlamentului, în special”, se mai arată în documentul citat.
Iniţiatorii consideră că „parlamentarii ar trebui să beneficieze, la fel ca toţi cetăţenii acestei ţări, exclusiv de pensie în sistemul public de pensii, pe bază de contributivitate”.
„Prezenta iniţiativă legislativă constituie un pas în vederea asigurării echităţii între cetăţeni, prin abrogarea articolelor referitoare la indemnizaţiile speciale ale parlamentarilor. Totodată, prin abrogarea acestor prevederi, se va înregistra un impact bugetar pozitiv, asigurând degrevarea bugetului de stat de plata unor sume consistente”, se mai arată în Expunerea de motive.
Potrivit acestui document, la nivelul anului 2022, după data de 10 iunie (odată cu aplicarea Deciziei CCR, nr. 261/2022) au fost achitate un număr de 583 de indemnizaţii, cu o valoare totală de 19.370.146,80 lei.
„Menţinerea în plată a acestor indemnizaţii ar pune presiune suplimentară pe bugetul de stat într-un context economic pus la grea încercare de crizele succesive sanitare, economice, geopolitice care s-au abătut asupra ţării noastre în ultimii ani”, mai arată iniţiatorii.
Comisia permanentă a Camerei Deputaţilor şi Senatului privind Statutul deputaţilor şi al senatorilor, organizarea şi funcţionarea şedinţelor comune ale Camerei Deputaţilor şi Senatului a emis raport în vederea adoptării proiectului, cu 7 voturi „pentru” şi o abţinere.
Potrivit unui anunţ oficial al PSD, la şedinşa comună va lua parte şi preşedintele social-democraţilor, premierul Marcel Ciolacu.
Anterior, de la ora 12.00, are loc Consiliul Politic Naţional al Partidului Social Democrat.
Şi structurile de conducere ale liberalilor se reunesc luni dimineaţă.
Potrivit programului oficial anunţat de PNL, de la ora 08.00, preşedintele PNL, preşedintele Senatului, Nicolae Ciucă, secretarul general, vicepreşedintele Camerei Deputaţilor, Lucian Bode, prim-vicepreşedinţii PNL, miniştri şi secretari de stat ai PNL vor la o şedinţă de coordonare a activităţii politice şi guvernamentale.
Ulterior, de la ora 11.00, se reuneşte Biroul Politic Naţional (BPN) al PNL.